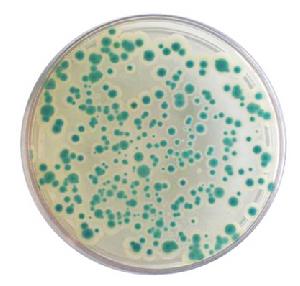
蠟樣芽孢桿菌顯色培養基

簡介?
蠟樣芽孢桿菌顯色培養基是海博生物改良的培養基,用於食品、水、乳製品和肉製品中蠟樣芽孢桿菌的快速檢測。蠟樣芽孢桿菌顯藍綠色且菌落比較大,蘇雲金芽孢桿菌顯藍綠色,李斯特氏菌顯深藍色,菌落比較小,其它菌顯黃色或無色,革蘭氏陰性菌被抑制。
成分(g/L)
?
| 特殊營養物質 | 41.9 |
| 顯色劑 | 0.5 |
| 抑菌劑 | 0.6 |
| 瓊脂 | 15.0 |
| pH 7.0±0.2 25℃ | |
注意事項及用法?
?
注意
此培養基僅供實驗室使用。此配方可以進行改良或增加營養成份以獲得最佳的結果。
用法
稱取本品 11.6g加入200ml蒸餾水,加熱溶解並不停攪拌,煮沸不要超過1分鐘。冷卻至45-50℃時,傾入無菌平皿,備用。
貯存
製備好的平板應立即使用,應避免光線直接照射。乾燥培養基應放置於陰暗乾燥處,保存溫度2-8℃,注意避光保存。
失效
乾燥培養基超過保質期、結塊和顏色變化都不能使用。
操作步驟?
1、按國家標準、SN標準、FDA標準或其它方法製備樣品液
2、樣品液在30±1℃增菌培養18-24小時;
3、取增菌液劃線接種於蠟樣芽孢桿菌顯色培養基平板上,30±1℃培養18~24h。蠟樣芽孢桿菌典型菌落為藍綠色且菌落比較大。若24小時沒有出現典型菌落,可延長培養至48小時。
4、對可疑蠟樣芽孢桿菌可劃線接種到營養瓊脂平板上,30±1℃培養18-24小時,挑取單菌落做蠟樣芽孢桿菌全套生化試驗(配有生化鑑定管套裝 7種x2套/盒*5盒)
質量控制與典型特徵?
1、外觀
此乾燥培養基的粉末均勻,具有良好的流動性,呈乳白色。製備好的平板呈透明無色固體培養基。
2、微生物試驗
在30±1℃培養18~24h小時:
| 質控菌株 | ATCC | 生長情況 | 菌落顏色 |
| 單增李氏菌 | 27853 | ++ | 深藍色,菌落比較小 |
| 金黃色葡萄球菌 | 25923 | -/+ | 白色 |
| 大腸桿菌 | 25922 | - | / |
| 蠟樣芽孢桿菌 | 11778 | +++ | 藍綠色,菌落比較大,扁平,有藍色中心 |
| 蘇雲金芽孢桿菌 | +++ | 藍綠色,菌落比較大,扁平,有藍色中心且有不規則邊緣 | |
| 枯草芽孢桿菌 | CMCC63501 | - | - |
典型特徵
蠟樣芽孢桿菌典型菌落為藍綠色有菌落比較大。
